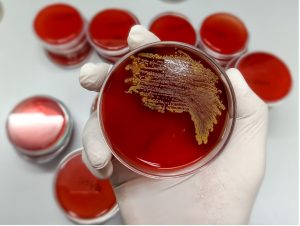
ngs vs standard urine culture

Urinary Tract Infections (UTIs) continue to pose a substantial healthcare burden worldwide and remain to be one of the most frequent infections seen globally. In the U.S., both adult male and female UTIs account for the most clinic visits every year. According to data gathered by the NIH, around 7 million annual clinic visits were due to UTIs, and there were more than 1 million UTI cases among children. UTIs also accounted for about 1 million urgent care visits and 100,000 hospitalization cases every year.
Because UTIs are often treated empirically — where patients are often prescribed antibiotics without a standard urine culture test — experts believe that the incorrect and thereby over-prescription of antibiotics for UTIs is one of the main contributors antibiotic resistance.
The inappropriate prescription of antibiotics was observed in half of UTI patients, according to the Journal of Hospital Medicine. This is concerning because there is an increasing prevalence of antibiotic-resistant UTIs that are difficult to treat; thus there is a need to improve the accuracy of antibiotic treatments for UTIs.
In recent years, research has also established the role of biofilm in UTIs. Temporary or permanently implanted medical devices in the urinary tract, such as urethral catheters, stents, etc., promote the accumulation and growth of biofilm. Bacteria in biofilms are highly tolerant and resistant to antibiotics, presenting another major challenge in treating UTIs.
Conventional UTI Diagnostic Methods
 Because UTIs are such a commonly occurring problem, there is a need for a high-accuracy diagnostic method to improve patient care and cope with the pressing issue of antibiotic-resistant bacteria. Conventionally, when a patient presents clinical symptoms associated with UTIs such as painful urination, changes in urine color, etc., urine analysis and standard urine culture (SUC) are methods used to detect the presence of pathogens.
Because UTIs are such a commonly occurring problem, there is a need for a high-accuracy diagnostic method to improve patient care and cope with the pressing issue of antibiotic-resistant bacteria. Conventionally, when a patient presents clinical symptoms associated with UTIs such as painful urination, changes in urine color, etc., urine analysis and standard urine culture (SUC) are methods used to detect the presence of pathogens.
Urine analysis involves urine dipsticks (which detect nitrite produced by pathogens and signs of inflammation) or microscopy. SUC, currently accepted as the ‘gold standard for diagnosing UTIs, involves the culturing and growth of microbes present in the urine samples onto culture dishes made of different types of nutrients under aerobic conditions (presence of oxygen).
Although SUC is routinely used in clinical practice today, studies have shown that those methods have alarmingly high error rates. This is due to several reasons:
- SUC has low sensitivity rates. Studies have shown that patients with UTI symptoms have a negative urine culture test nearly half the time.
- SUC result in selective biases; the standard culture dishes are not suited to culture certain ‘atypical’ microbes, fungus, and anaerobic microorganisms.
- SUC is, is easily contaminated by vaginal, fecal, epidermal, or even perianal microbes, or simply due to poorer urine collection, storage, and transport techniques, resulting in false positives. A study performed at Stanford University showed that about 30% of SUC were found to be contaminated.
- There are differences across different institutions regarding the microbial colony count threshold to be deemed as clinically significant.
Because of the numerous limitations to current UTI diagnostic methods, patients experience delays in diagnosis and are not receiving optimal care and treatment. This further exacerbates the disease burden of UTIs.
NGS vs. Standard Urine Culture
MicroGenDX’s NGS has made tremendous headway in UTI diagnostics, providing a significantly more accurate and comprehensive method of detection over traditional methods such as SUC. Since each pathogen has a unique genetic make-up that allows for identification, genetic sequences detected by NGS are compared against a large database of known microbe sequences, regardless of their abundance in patient samples.
MicroGenDX’s NGS has made tremendous headway in UTI diagnostics, providing a significantly more accurate and comprehensive method of detection over traditional methods such as SUC. Since each pathogen has a unique genetic make-up that allows for identification, genetic sequences detected by NGS are compared against a large database of known microbe sequences, regardless of their abundance in patient samples.
A head-to-head comparison study published in Reviews of Urology showed that NGS had a 100% success in detecting acute cystitis while the SUC only had 30% success rate.
Ruth Kriz, MSN, APRN, a specialist in treating Interstitial Cystitis, says that “With NGS, we don’t have that ambiguity, we don’t have human errors being introduced and we don’t have any selection bias of what will or will not grow [on standard urine cultures].”
Unlike SUC, MicroGenDX NGS is able to capture information about antibiotic-resistance from the genome of microbes. In addition, MicroGenDX NGS is able to identify microbes in biofilms, which are traditionally difficult to culture, and treat biofilm infections.
MicroGenDX NGS is also able to exclude UTIs from the diagnosis of other urologic diseases that present similar symptoms such as Interstitial Cystitis (caused by defective lining of the bladder).
Collectively, increasing the accuracy of UTI diagnosis will improve patient outcomes by providing appropriate treatment options and prevent inaccurate and over-prescription of antibiotics.
How MicroGenDX Can Help You Diagnose and Treat Urologic Diseases
 MicroGenDX, the industry leader in molecular diagnosis of infections, offers a state-of-the-art solution to accurately diagnose urologic diseases such as UTIs. By combining two advanced technologies — qPCR+NGS — MicroGenDX is able to provide both rapid and in-depth screening of microbial DNA sequences.
MicroGenDX, the industry leader in molecular diagnosis of infections, offers a state-of-the-art solution to accurately diagnose urologic diseases such as UTIs. By combining two advanced technologies — qPCR+NGS — MicroGenDX is able to provide both rapid and in-depth screening of microbial DNA sequences.
Not only will MicroGenDX be able to identify the types of pathogens present, there will also be information about drug resistance, allowing physicians to make informed and precise decisions regarding treatment; all within a single test.
The two common misconceptions physicians have about NGS are that there are long turnover rates and that the reports are too complicated. However, MicroGenDX has an average turnover time of 3.5 days and there are resources provided to physicians who are new to the service.
Many medical professionals have expressed confidence in using MicroGenDX to accurately diagnose and treat urologic diseases. Timothy Hlavinka, M.D., a urologist at the Urology Place in San Antonio, Texas, says that “traditional anti-microbial culture and testing sensitivity has just failed to show me what I need,” and that MicroGenDX “has been the best thing that has happened” in the field of urology.
Ginger Isom-Batz, M.D., a urologist at the Urology Clinics of North Texas in Dallas says that MicroGenDX has helped her patients have confidence in her abilities and decisions in treating their urologic conditions.
MicroGenDX’s qPCR+NGS has brought about tremendous positive changes to how urologists approach urologic diseases. This will ultimately translate into more timely delivery of treatments to patients and higher quality patient care.
Read: Next-Generation Sequencing Helps Clinicians Win the War Against Biofilm Infections



